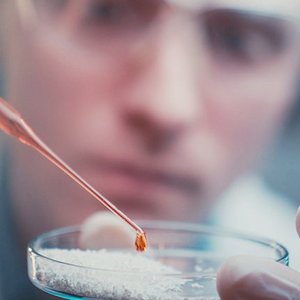

The Regeneration Company
Geistlich is a world-leading medtech company in medical regeneration based in Switzerland. With passionate commitment, Geistlich develops, manufactures, and distributes cutting-edge medical devices for the regeneration of bone, cartilage, and tissue.